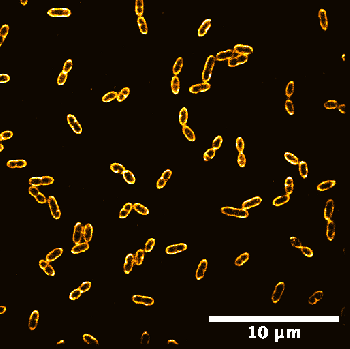
Averaged shifted histograms.tif_zoom_movie

L. lactis PAINTed with Nile-Red. Work by Ben Tumulero and others. ImageJ/FIJI plugin by Andrey Aristov (Pasteur) based on scripts by Eugene Katrukha (Utrecht).

L. lactis PAINTed with Nile-Red. Work by Ben Tumulero and others. ImageJ/FIJI plugin by Andrey Aristov (Pasteur) based on scripts by Eugene Katrukha (Utrecht).